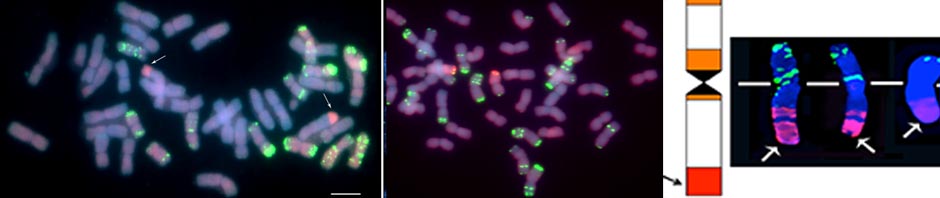

318. Patokar C, Sepsi A, Schwarzacher T, Kishii M, Heslop-Harrison JS. 2016. Molecular cytogenetic characterization of novel wheat-Thinopyrum bessarabicum recombinant lines carrying intercalary translocations. Chromosoma 125: 163–172. 10.1007/s00412-015-0537-6 Publisher website. Version from Wheat-Thinopyrum introgression and chromosomal recombinants.
Thinopyrum bessarabicum (2n=2x=14, JJ or EbEb) is a valuable source of genes for bread wheat (2n = 6x=42) improvement because of its salinity tolerance and disease resistance. Development of wheat–Th. bessarabicum translocation lines by backcrossing the amphiploid in the absence of the Ph1 gene (allowing intergenomic recombination) can assist its utilization in wheat improvement. In this study, six novel wheat–Th. bessarabicum translocation lines involving different chromosome segments (T4BS.4BL-4JL, T6BS.6BL-6JL, T5AS.5AL-5JL, T5DL.5DS-5JS, T2BS.2BL-2JL, and the whole arm translocation T1JS.1AL) were identified and characterized using genomic in situ hybridization (GISH) and fluorescent in situ hybridization (FISH). No background translocations between wheat genomes were observed. The involvement of 5 of the 7 chromosomes, and small terminal segments of Th. bessarabicum chromosome arm were important, contributing to both reduced linkage drag of the derived lines by minimizing agronomically deleterious genes from the alien species, and high stability including transmission of the alien segment. All three wheat genomes were involved in the translocations with the alien chromosome, and GISH showed the Th. bessarabicum genome was more closely related to the D genome in wheat. All the introgression lines were disomic, stable and with good morphological characters.
Keyword: FISH, cytogenetics, wheat/alien introgression, background translocation, recombinant chromosome, linkage drag, salt tolerance.
Adverts below not associated with website
